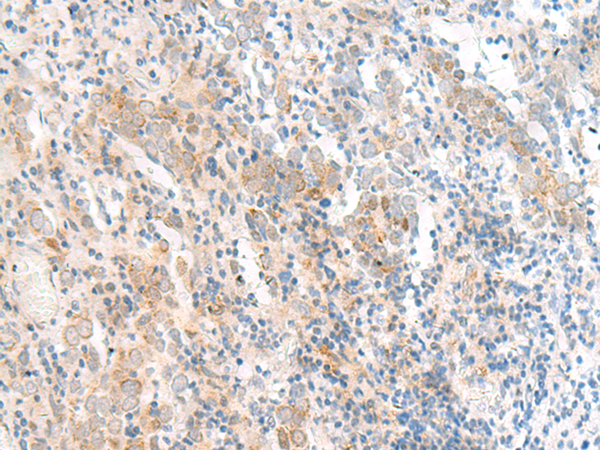
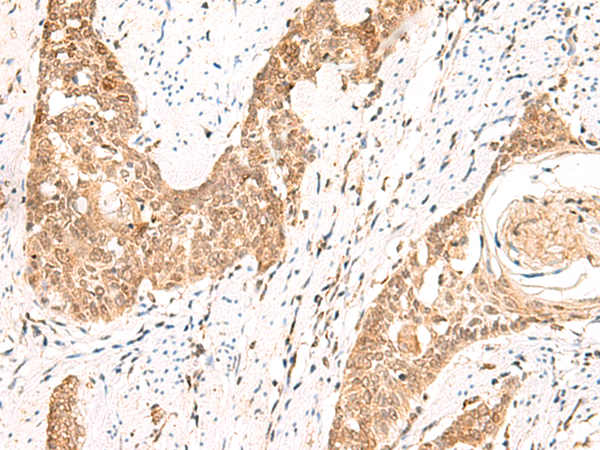

-
分类: 科研抗体货号: P03102别名: PEG1应用: WB,IHC反应种属: Human, Mouse, Rat
-
分类: 科研抗体货号: P03007别名: MRP-L50应用: IHC反应种属: Human
-
分类: 科研抗体货号: P02928别名: PTAR3应用: WB,IHC反应种属: Human, Mouse, Rat
-
分类: 科研抗体货号: P03096别名: PIG54; SCC112; SCC-112应用: IHC反应种属: Human, Mouse, Rat
-
分类: 科研抗体货号: P03005别名: FIL1; FIL1D; IL1F5; IL1L1; PSORP; IL1HY1; IL1RP3; IL36RA; IL-36Ra; PSORS14; FIL1(DELTA)应用: WB反应种属: Human, Mouse, Rat
-
分类: 科研抗体货号: P02927别名: EIF3EIP; EIF3S11; HSPC021; HSPC025; MSTP005; EIF3S6IP应用: IHC反应种属: Human, Mouse
-
分类: 科研抗体货号: P03086别名: PTG; PPP1R5应用: IHC反应种属: Human, Mouse, Rat
-
分类: 科研抗体货号: P03001别名:应用: IHC反应种属: Human
-
分类: 科研抗体货号: P02923别名: HMFN1661应用: WB反应种属: Human, Mouse, Rat
-
分类: 科研抗体货号: P03074别名: HYPP; HOKPP; MiRP2应用: IHC反应种属: Human, Mouse, Rat

鄂公网安备42018502007531号
鄂公网安备42018502007531号

